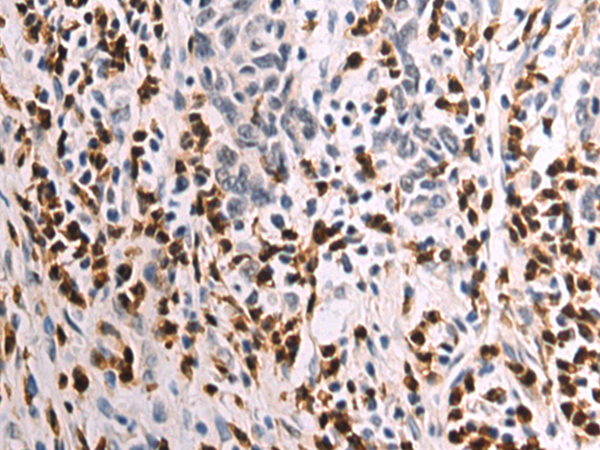

-
分类: 科研抗体货号: P00253别名: p33(CDK2)应用: WB,IHC反应种属: Human, Mouse, Rat
-
分类: 科研抗体货号: P00250别名: MEC, CCK1, SCYA28应用: WB反应种属: Human
-
分类: 科研抗体货号: P00295别名: CREB应用: WB反应种属: Human, Mouse, Rat
-
分类: 科研抗体货号: P00249别名: TECK; Ckb15; SCYA25应用: IHC反应种属: Human
-
分类: 科研抗体货号: P00287别名: CLDNL; hCG1646163应用: WB,IHC反应种属: Human
-
分类: 科研抗体货号: P00247别名: Ckb-6, MPIF2, MPIF-2, SCYA24应用: WB反应种属: Human
-
分类: 科研抗体货号: P00283别名:应用: WB,IHC反应种属: Human, Mouse, Rat
-
分类: 科研抗体货号: P00244别名:应用: IHC反应种属: Human, Mouse
-
分类: 科研抗体货号: P00278别名: HML; MGL; HML2; CD301; CLECSF13; CLECSF14应用: WB,IHC反应种属: Human
-
分类: 科研抗体货号: P00243别名: M33; CDCA6; SRXY5应用: WB,IHC反应种属: Human

鄂公网安备42018502007531号
鄂公网安备42018502007531号

